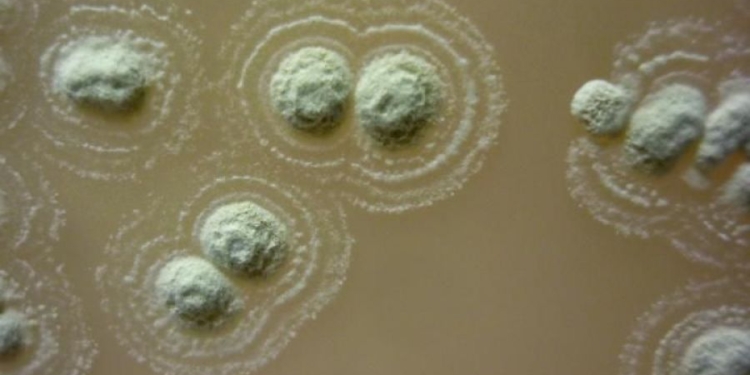
В Ирландии нашли бактерию, которая побеждает суперинфекции

Исследователи, изучившие почву в одном из регионов Ирландии, обнаружили бактерию, которая подавляет рост ESKAPE-патогенов, устойчивых к большинству известных антибиотиков.
Микроорганизм выделили из почвы в Северной Ирландии, которую использовали в традиционной медицине, говорится в статье EurekAlert!.
Всемирная организация здравоохранения (ВОЗ) описывает проблему супербактерий как “одну из самых больших угроз для глобального здравоохранения, продовольственной безопасности и развития”. Поиск веществ для борьбы с множественной резистентностью побудил исследователей изучить новые источники, в том числе народные лекарства. Эта область исследований известна как этнофармакология.
Новый штамм бактерий был обнаружен командой из Медицинской школы университета Суонси, в состав которой входят исследователи из Уэльса, Бразилии, Ирака и Северной Ирландии. Они назвали новый штамм Streptomyces sp. myrophorea.
Почва, которую они проанализировали, происходила из графства Фермана, Северная Ирландия, которое известно также как высокогорье Бохо. Это область щелочных пастбищ, и почва здесь, как считалось, имеет целебные свойства. Один из исследователей, доктор Джерри Куинн, бывший житель графства Фермана, много лет знал о традициях целителей этого района.
Штамм бактерий, обнаруженный в почве, оказался эффективен в борьбе с четырьмя из шести устойчивых к антибиотикам патогенов, которые вызывают опасные заболевания. Среди них энтерококк фэциум (Enterococcus faecium), золотистый стафилококк (Staphylococcus aureus), а также клибсиелла пневмонии (Klebsiella pneumoniae).
“Этот новый штамм бактерий эффективен против 4 из 6 лучших патогенов, устойчивых к антибиотикам, включая MRSA. Наше открытие является важным шагом вперед в борьбе с устойчивостью к антибиотикам. Наши результаты показывают, что фольклорные и традиционные лекарства заслуживают изучения в поисках новых антибиотиков”, – сказал профессор Пол Дайсон из Медицинской школы университета Суонси.
Кроме того, Streptomyces sp. myrophorea способна подавлять рост как грамположительных, так и грамотрицательных бактерий, которые различаются по структуре их клеточной стенки. Обычно грамотрицательные бактерии более устойчивы к антибиотикам.
Ранее ученые разработали имплантат, который помогает похудеть.